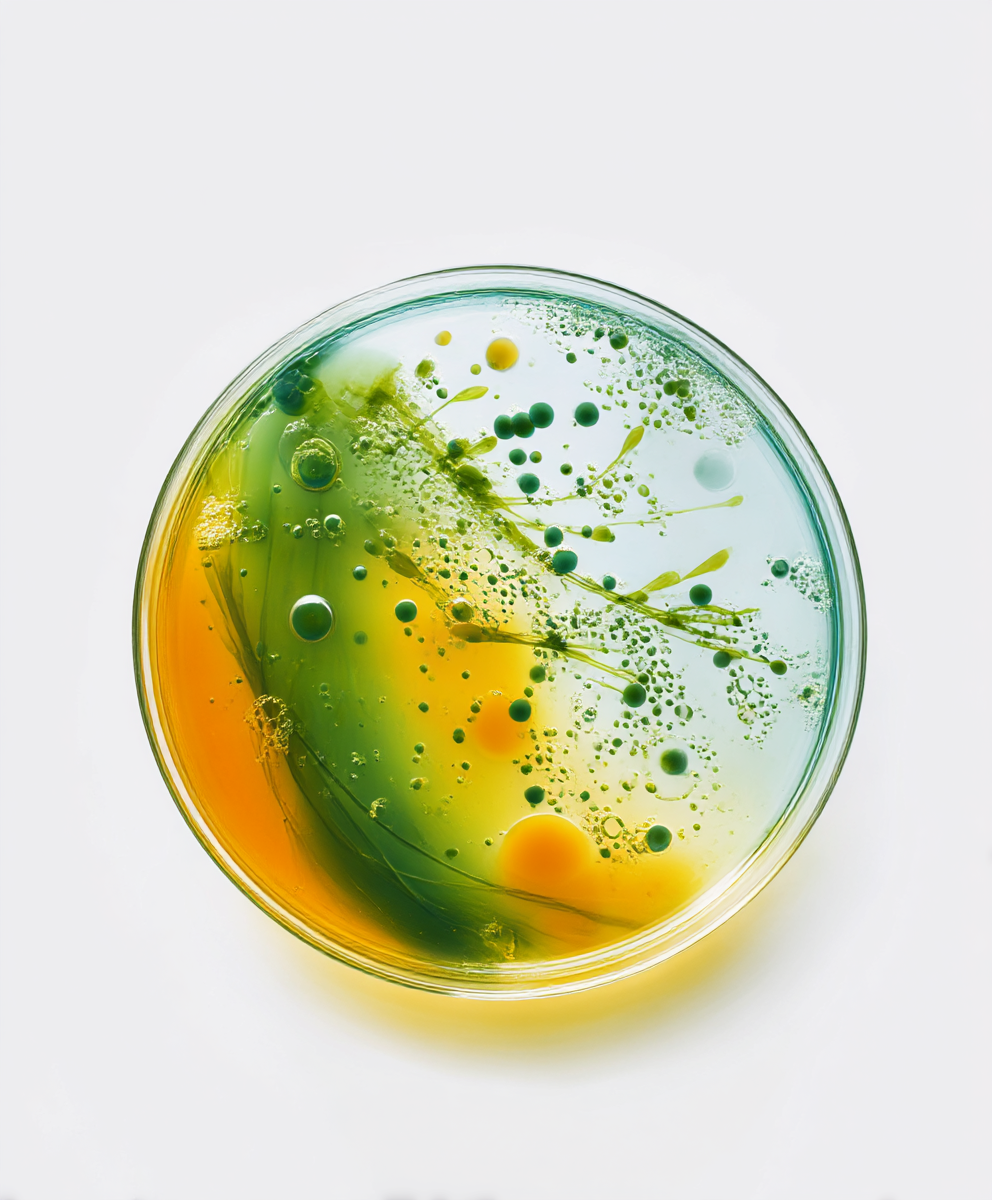

Estrategia de marca
Arquitectura de marca
Dirección de arte
IA generativa
Identidad visual
Sistema visual
Diseño gráfico
Instru
Instru vende, distribuye, calibra y mantiene instrumentación de análisis para sectores como farmacia, medioambiente, petroquímica, química, gases, agroalimentario y energía. Mi trabajo consistió en definir la estrategia de marca (Brand Essence) y transformar su identidad visual —de Instrumentación Analítica a INSTRU— en un sistema claro, técnico y cercano que pudiera escalar en comunicación, comercial y digital.
Como Design Manager & Brand Strategist, lideré la definición del propósito, valores, personalidad y tono; la arquitectura por sectores; y la traducción de todo ello a un Sistema visual sólido. El resultado: un framework de marca que ordena la complejidad del portfolio y permite producir piezas coherentes.
En identidad, diseñé: logotipo y su retícula, la paleta cromática de base mineral (con matices “alga marina” y “arena”), la tipografía Satoshi y un sistema de iconografía funcional. Para el lenguaje visual, desarrollé una biblioteca de texturas creadas con IA generativa que representan procesos de análisis (fluidos, emulsiones, partículas, trazas) y codifican cada vertical de negocio. Estas visuales actúan como capa narrativa en campañas, presentaciones y social media, evitando el stock genérico y reforzando la diferenciación.
El proyecto se materializó en un manual de marca, plantillas y guías, papelería y credenciales, piezas para ferias (roll-ups, paneles, stand), merch, social media kits, y UI para web y materiales comerciales.
Impacto: una marca más legible y reconocible, con un sistema que acelera la creación de contenido, alinea equipos y proyecta la fiabilidad técnica y el compromiso de servicio de INSTRU.